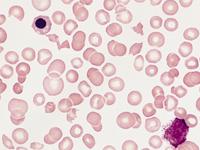
血小板减少症

血小板减少症能吃猪肝吗
分享者:走着散了
更新时间:2016-12-14 16:19:08
226阅读
- 概述
-
血小板是由骨髓中成熟的巨核细胞的细胞质脱落而成的。血小板减少原因可能有药物影响骨髓功能、营养素缺乏等,那么血小板减少症能吃猪肝吗?下面我来跟大家讲一讲。
- 血小板减少症能吃猪肝吗
-
第一,猪肝富含铁,血小板减少性紫癜是可以吃猪肝的,但是猪肝中毒素的蓄积比较多所以建议最好是少量的食用一点点就可以了,平时可以适量食用猪、牛、羊动物的瘦肉和动物的全血也是可以起到补充铁的效果,另外补铁的同时建议食用适量富含维生素C的食物以便能促进铁的吸收。

-
第二,患者可以吃长山药,饮食宜软而细。如有消化道出血,应给予半流质或流质饮食,宜凉不宜热。脾虚可稍多进肉、蛋、禽等滋补品,但亦要注意不要过于温补。有热可给蔬菜水果、绿豆汤、莲子粥,忌用发物如鱼、虾、蟹、腥味之食物。 多吃花生,花生衣能对抗纤维蛋白的溶解,促进骨髓造血机能,增加血小板的含量,对出血及出血引起的贫血有明显疗效。

-
第三,可以吃高蛋白膳食,瘦肉、动物肝脏、蛋及豆制品等优质蛋白质应充分保证。可以吃高维生素食品,尤其是含维生素C的食物对于维持血管正常功能有重要作用。

- 注意事项
-
避免吃粗硬食物、油炸、刺激性食物。甲鱼则含有大量的蛋白质、氨基酸、维生素以及大量的微量元素,因此可以吃甲鱼。但脾虚可稍多进肉、蛋、禽等滋补品,也要注意不要过于温补。
温馨提示:以上经验分享由网友原创分享,仅供参考,未经许可禁止转载,违者必究
相关图片
热门资讯
还有疑问?可免费咨询医生为你解答
最新经验
more+
- 漂亮的姑娘刚刚分享了经验 “ 轻型地中海贫血有哪些... ” 2018-01-15
- 花女人刚刚分享了经验 “ 一个月大的小孩贫血会... ” 2017-12-18
- 天有情刚刚分享了经验 “ 十一月婴贫血什么症状 ” 2017-12-13
- 专属权刚刚分享了经验 “ 静止型地贫有什么症状 ” 2017-12-05
- 画皮刚刚分享了经验 “ 宝宝先天性贫血是什么... ” 2017-12-01